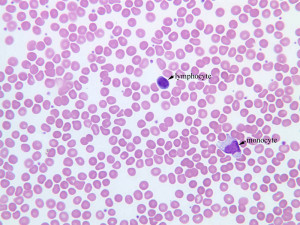
Human Blood Smear Under Microscope
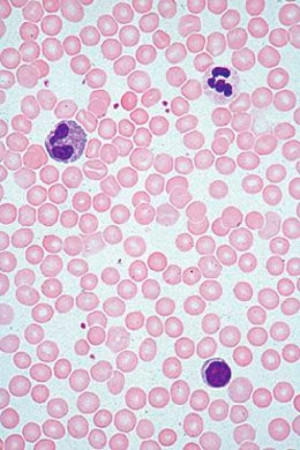
human blood smear under microscope
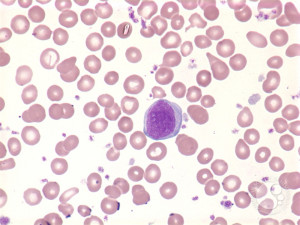
Myelofibrosis Peripheral Blood Smear

Smear Quotes
Will they attack us? Yes. Will they smear our backgrounds and distort our records? Undoubtedly. Will they lie about us, harass our families, namecall to try to intimidate us? They will. There's nothing safe about it. But is it worth it? Well, let me ask you. Is freedom worth it? Is America worth it?
The way the Establishment deals with people like me is to ignore them. When you become unignorable, they will try to smear you, and that's what I feared for a long time. Now I have somehow vaulted into this space where it's difficult for someone to smear me because it would look as though they were being vindictive and spiteful.